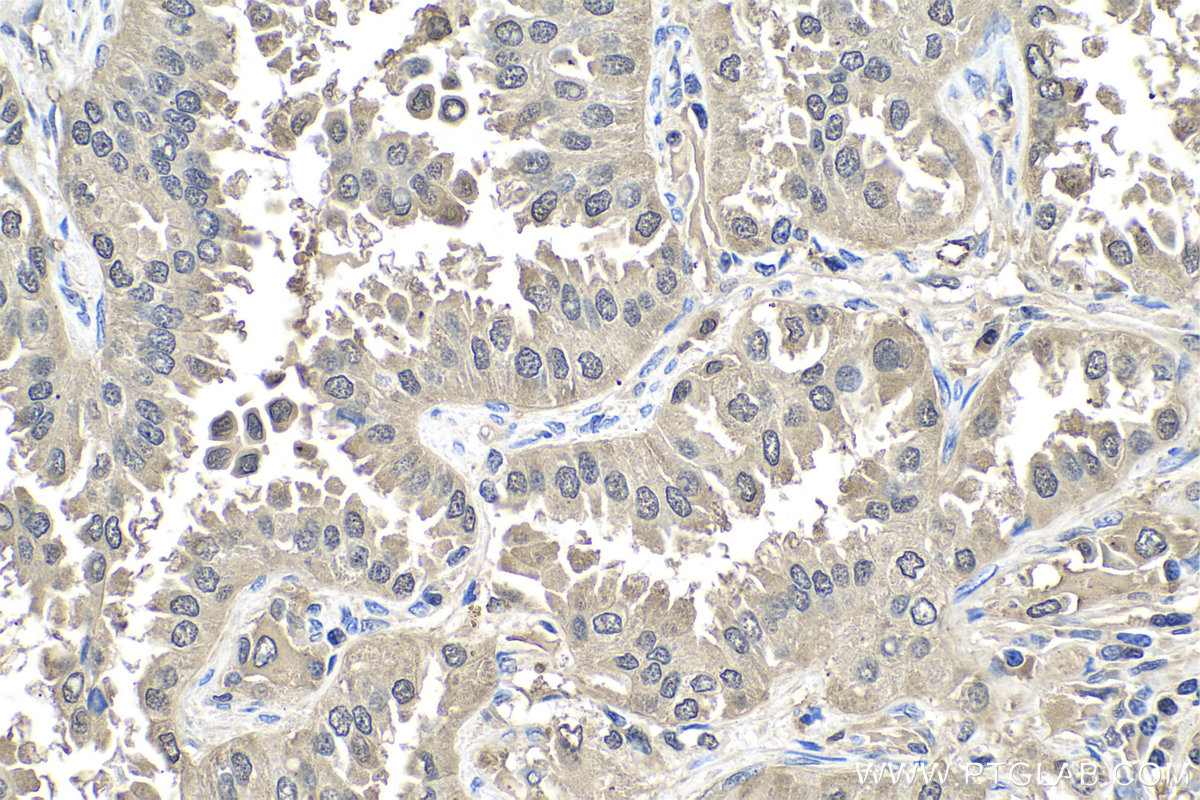

验证数据展示
经过测试的应用
| Positive WB detected in | DU 145 cells, HCT 116 cells, BxPC-3 cells, human lung tissue, HEK-293 cells, human heart tissue, COLO 320 cells, HaCaT cells, U2OS cells, SKOV-3 cells |
| Positive IP detected in | DU 145 cells, PC-3 cells |
| Positive IHC detected in | human breast cancer tissue, human cervical cancer tissue, human colon tissue, human colon cancer tissue, human liver cancer tissue, human lung cancer tissue, human ovary tumor tissue, human thyroid cancer tissue, mouse kidney tissue, rat kidney tissue Note: suggested antigen retrieval with TE buffer pH 9.0; (*) Alternatively, antigen retrieval may be performed with citrate buffer pH 6.0 |
| Positive IF/ICC detected in | PC-3 cells, BxPC-3 cells |
| Positive FC (Intra) detected in | PC-3 cells |
推荐稀释比
| 应用 | 推荐稀释比 |
|---|---|
| Western Blot (WB) | WB : 1:2000-1:12000 |
| Immunoprecipitation (IP) | IP : 0.5-4.0 ug for 1.0-3.0 mg of total protein lysate |
| Immunohistochemistry (IHC) | IHC : 1:50-1:500 |
| Immunofluorescence (IF)/ICC | IF/ICC : 1:200-1:800 |
| Flow Cytometry (FC) (INTRA) | FC (INTRA) : 0.80 ug per 10^6 cells in a 100 µl suspension |
| It is recommended that this reagent should be titrated in each testing system to obtain optimal results. | |
| Sample-dependent, Check data in validation data gallery. | |
产品信息
10237-1-AP targets S100A11 in WB, IHC, IF/ICC, FC (Intra), IP, CoIP, Neutralization, ELISA applications and shows reactivity with human, mouse, rat samples.
| 经测试应用 | WB, IHC, IF/ICC, FC (Intra), IP, ELISA Application Description |
| 文献引用应用 | WB, IHC, IF, IP, CoIP, Neutralization |
| 经测试反应性 | human, mouse, rat |
| 文献引用反应性 | human, mouse, rat |
| 免疫原 |
CatNo: Ag0343 Product name: Recombinant human S100A11 protein Source: e coli.-derived, PGEX-4T Tag: GST Domain: 3-105 aa of BC001410 Sequence: KISSPTETERCIESLIAVFQKYAGKDGYNYTLSKTEFLSFMNTELAAFTKNQKDPGVLDRMMKKLDTNSDGQLDFSEFLNLIGGLAMACHDSFLKAVPSQKRT 种属同源性预测 |
| 宿主/亚型 | Rabbit / IgG |
| 抗体类别 | Polyclonal |
| 产品类型 | Antibody |
| 全称 | S100 calcium binding protein A11 |
| 别名 | Calgizzarin, MLN 70, MLN70, Protein S100 A11, Protein S100 C |
| 计算分子量 | 105 aa, 12 kDa |
| 观测分子量 | 12 kDa |
| GenBank蛋白编号 | BC001410 |
| 基因名称 | S100A11 |
| Gene ID (NCBI) | 6282 |
| RRID | AB_2183478 |
| 偶联类型 | Unconjugated |
| 形式 | Liquid |
| 纯化方式 | Antigen affinity purification |
| UNIPROT ID | P31949 |
| 储存缓冲液 | PBS with 0.02% sodium azide and 50% glycerol, pH 7.3. |
| 储存条件 | Store at -20°C. Stable for one year after shipment. Aliquoting is unnecessary for -20oC storage. |
背景介绍
S100A11 (also known as S100C or calziggarin), is a member of the S100 family of proteins containing 2 EF-hand calcium-binding motifs (PMID: 18694925). S100 proteins are localized in the cytoplasm and/or nucleus of a wide range of cells, and involved in the regulation of a number of cellular processes such as cell cycle progression and differentiation. First discovered in 1989, S100A11 has since been proposed to have direct biological functions in an assortment of physiological processes such as endo- and exocytosis, regulation of enzyme activity, cell growth and regulation, apoptosis and inflammation (PMID: 15241500). Chromosomal rearrangements and altered expression of S100A11 have been implicated in tumor metastasis. This S100A11 antibody (10237-1-AP) has also been instrumental in investigations into S100A11's role in the development of brain tumors in tuberous sclerosis complex (TSC) patients (PMID: 20133820).
实验方案
| Product Specific Protocols | |
|---|---|
| IF protocol for S100A11 antibody 10237-1-AP | Download protocol |
| IHC protocol for S100A11 antibody 10237-1-AP | Download protocol |
| IP protocol for S100A11 antibody 10237-1-AP | Download protocol |
| WB protocol for S100A11 antibody 10237-1-AP | Download protocol |
| Standard Protocols | |
|---|---|
| Click here to view our Standard Protocols |
发表文章
| Species | Application | Title |
|---|---|---|
Nat Commun S100A11 is required for efficient plasma membrane repair and survival of invasive cancer cells. | ||
Dev Cell Annexin A1 Tethers Membrane Contact Sites that Mediate ER to Endosome Cholesterol Transport. | ||
J Pathol Tissue-based proteomics reveals FXYD3, S100A11 and GSTM3 as novel markers for regional lymph node metastasis in colon cancer. | ||
Mol Cell Proteomics S100A11 mediates hypoxia-induced mitogenic factor (HIMF)-induced smooth muscle cell migration, vesicular exocytosis, and nuclear activation. | ||
Cell Mol Gastroenterol Hepatol S100A11 Promotes Liver Steatosis via FOXO1-Mediated Autophagy and Lipogenesis. | ||
J Clin Endocrinol Metab Down-regulation of S100A11, a calcium-binding protein, in human endometrium may cause reproductive failure. |